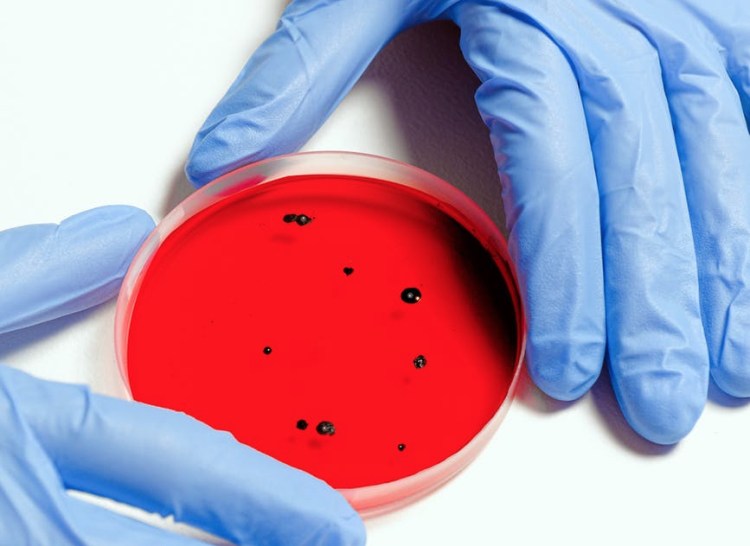

… Das ist hier die Frage. Überraschungsabräumer bei der Oscar-Verleihung 2020 ist der koreanische Film „Parasite“, eine geniale Mischung aus Slapstick, Hitchcock und Sozialkritik. Darum geht’s:
Die Schmarotzer oder „Parasiten“ sind eine lustige und listige arme Familie, die sich mit Lug und Trug, aber sympathisch bei Reichen einnisten. Dies gelingt ihnen durch ein kooperatives und höchst planvolles Vorgehen.
Dann geschieht etwas, was nicht eingeplant war: Im Luftschutzkeller der Reichen entdecken sie einen weiteren Schmarotzer, der dort schon mehrere Jahre sein Parasitendasein führt. Anstatt dass die Armen kooperieren, bekämpfen sie sich. Der Plan der Armen, als Parasit zu leben, gerät außer Kontrolle.
Am Tiefpunkt der Geschichte findet sich die arme Familie in einer Notunterkunft mit vielen anderen wieder. Eine Überschwemmung hat sie dorthin gezwungen. Da entspinnt sich eine Unterhaltung zwischen Vater und Sohn:
„Vater, was machen wir jetzt? Du hattest doch einen Plan!“ Der Vater, der anfangs noch angegeben hatte, zu wissen, was er wolle, antwortet: „Weißt du, welcher Plan immer funktioniert? Der Kein-Plan. Schau dir diese Menschen an. Sie hatten nicht geplant, die Nacht in dieser Turnhalle zu verbringen. Aber jetzt sind sie hier, obowhl sie es nicht geplant hatten. Immer wenn du im Leben einen Plan machst, kommt alles ganz anders. Deshalb sollte man keine Pläne schmieden. Denn dann kann nichts schief gehen.“
Dies klingt auf den ersten Blick gar nicht so schlecht. Ist das nicht buddhistische Gelassenheit oder stoischer Gleichmut? Das kluge Sichverkrümeln angesichts unüberwindlicher Schwierigkeiten?
Schauen wir genauer hin: Der Kein-Plan ist darf nicht verwechselt werden mit einer stoischen Constanzia, deren Plan darin besteht, sich nicht aus der Ruhe zu bringen lassen, komme, was da wolle. Oder mit einer aus Meditation gewonnener Leidenschaftslosigkeit – Apathia – , deren Plan es ist, ins Nirwana einzugehen oder Gott und den Nächsten in innerem Frieden zu lieben. Der Kein-Plan ist auch nicht zu verwechseln mit der Entscheidung mancher Schulabgänger, die erstmal keinen Plan haben wollen, nachdem sie ihr ganzes Schülerleben verplant wurden. Auch nicht mit der Aussage von Indiana Jones, der auf die Frage „Do you have a plan?“ im Losrennen ruft: „No, I’m making this up as I go!“ Auch das ist ein Plan.
Nein, die Kein-Plan Philosophie des sympathischen Vaters Kim Ki-taek im Film Parasite ist die bittere Selbstaufgabe eines Mannes, der alles im Leben versucht hat und sich nun frustriert dem Würgegriff der Existenz überlässt.
So jedenfalls sieht es der Film, denn: Ab dem Kein-Plan-Gespräch zwischen Vater und Sohn, gemäß dem doch eigentlich nichts mehr schief gehen kann, geht einfach alles schief: Der Vater landet im Keller der Reichen, wo er ausdrücklich nie hinwollte („Wie kann man hier leben?“). Der Sohn verfängt sich in einer unerreichbaren Lebenslüge und will reich werden, die Tochter stirbt und die Mutter muss wieder putzen.
Übrigens: Auch die reiche Familie Park kommt im Film nicht gut weg. Mutter Park hat offensichtlich keinen Plan, lässt sich von jedem leicht um den Finger wickeln und agiert als schönes Möbel im Designer-Haus. Vater Park hat in einer Handy-Firma eine leitende Stellung, die sich „another brick“ nennt, eine Anspielung auf den Pink Floyd-Song „Another brick in the wall“. Selbst nur ein Backstein in der Wand des Systems, liebt er seine Frau nur oberflächlich. An den Armen stört ihn vornehmlich der Geruch – mehr Gedanken hat er sich über sie offenbar nicht gemacht.
Fazit: In einer Gesellschaft wie der von Südkorea, wo der Film spielt und wo die gesellschaftlichen Erwartungen besonders hoch sind, ist es offenbar für Arm und Reich schwer, wirklich proaktiv zu leben und seinen Sinn zu finden. Und genau daran leiden diese Menschen in dem wunderbaren Film „Parasite“.